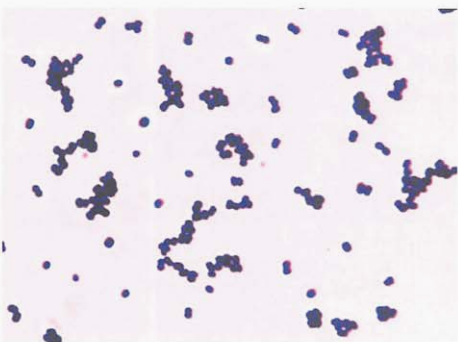
图 1绿色气球菌纯培养的镜下形态(革兰染色)
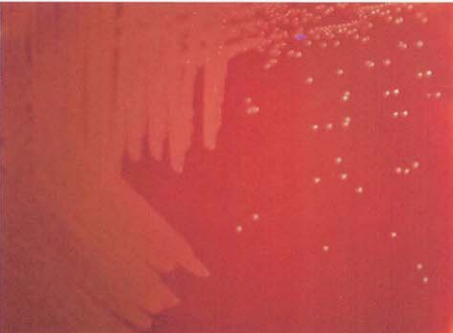
图 4 溶血李生球菌在血琼脂平板上的菌落特征(18~24h)
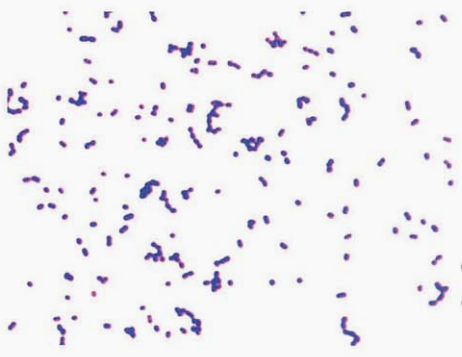
图 5麻疹孪生球菌纯培养镜下形态(革兰染色)

4种典型球菌的染色形态、培养特征和生化反应等介绍
来源:武汉市灰藻生物科技有限公司 浏览量:26 发布时间:2026-01-30 13:17:48
绿色气球菌 A. viridans
(一) 绿色气球菌形态与染色
革兰阳性球菌,直径1.0~2.0μm,多呈四联状或成簇排列,亦可单个、成对排列,液体培养更倾向于四联状排列(图 1)。
图 1绿色气球菌纯培养的镜下形态(革兰染色)
(二) 绿色气球菌培养特性
在血琼脂平板上35℃培养18~24h,形成圆形、凸起、针尖样大小小菌落,草绿色溶血环不明显,48h后菌落增大至1 mm,灰白色,草绿色溶血环明显(图 2),肉汤培养24h后呈均匀浑浊生长。

图 2绿色气球菌在血琼脂平板上的菌落特征(48h)
(三) 绿色气球菌生化反应
触酶阴性或弱阳性,可在pH9.6肉汤和40%胆汁中生长,精氨酸双水解酶试验和VP试验均为阴性。主要生化反应见表 1。
| 试验 | 结果 | 试验 | 结果 |
|---|---|---|---|
| 氧化酶 | — | β葡萄糖醛酸苷酶 | ND |
| 葡萄糖 | + | 40%胆汁生长 | V |
| 试验 | 结果 | 试验 | 结果 |
|---|---|---|---|
| 6.5% NaCl生长 | + | 七叶苷 | + |
| 吡咯烷酮芳基酰胺酶 | + | 马尿酸钠 | V |
| 亮氨酸氨基肽酶 | — | 万古霉素 | S |
注: +,90%以上菌株阳性; —,90%以上菌株阴性; V,反应不定(11%~80%菌株为阳性); ND,无资料; S,敏感
(四) 绿色气球菌鉴别要点
1. 本菌特征
革兰阳性球菌,草绿色溶血环,PYR阳性,6.5% NaCl肉汤中生长。
2. 与肠球菌属的鉴别
绿色气球菌亮氨酸氨基肽酶试验阴性,而肠球菌则相反。
3. 与其他气球菌的鉴别
见表 2。
| 菌名 | PYR | LAP | β葡萄糖醛酸苷酶 | 40%胆盐生长 | 七叶苷 | 马尿酸钠 | 万古霉素 |
|---|---|---|---|---|---|---|---|
| 柯气球菌 | — | + | — | — | — | + | S |
| 血气球菌 | 100 | 100 | + | 100 | 100 | 94 | ND |
| 尿气球菌 | 0 | 100 | + | 0 | 11 | 93 | S |
| 人尿气球菌 | — | — | + | — | + | + | ND |
| 绿色气球菌 | 100 | 0 | ND | 80 | 90 | 75 | S |
注: +,90%以上菌株阳性; —,90%以上菌株阴性; 数字为测试菌株阳性率(%); ND,无资料; S,敏感
4. 气球菌及相关菌鉴别
见表 3。
| 菌名 | 球杆状 | 杆状 | 葡萄糖产气 | 万古霉素 | 胆汁七叶苷 | PYR | 黄色素 | LAP |
|---|---|---|---|---|---|---|---|---|
| 气球菌属 | — | — | — | S | V | —/+ | — | +/- |
| 乳球菌属 | + | — | — | S | V | V | — | + |
| 片球菌属 | — | — | — | R | + | — | — | + |
| 链球菌属 | + | + | — | S | V | V | — | + |
| 无色藻菌属 | + | + | + | R | + | — | — | — |
| 孪生球菌属 | — | — | — | S | — | + | — | + |
| 创伤球菌属 | — | — | — | S | V | + | — | — |
| 肠球菌属 | + | — | — | S | + | + | —/+ | + |
注: +,90%以上菌株阳性; —,90%以上菌株阴性; V,反应不定(11%~80%菌株为阳性); S,敏感; R,耐药; —/+,多数阴性,少数阳性; +/- ,多数阳性,少数阴性。PYR,吡咯烷酮芳基酰胺酶; LAP,亮氨酸氨基肽酶
(五) 绿色气球菌药敏试验的药物种类选择
绿色气球菌药敏试验的药物种类选择见表 4。
| 类别 | 抗菌药物名称 |
|---|---|
| 必选 | 青霉素、头孢曲松、万古霉素 |
| 可选 | 头孢噻肟、美罗培南、环丙沙星、左氧氟沙星、复方磺胺甲噁唑、利奈唑胺 |
| 天然耐药 | 氨基糖苷类、红霉素、四环素 |
注: 上述药物只有MIC判读折点,具体参照CLSI M45 - A3最新版本文件
(六) 绿色气球菌结果解释与要点提示
(1) 绿色气球菌广泛分布于空气和土壤,可引起心内膜炎、泌尿道感染、脓毒性关节炎、脑膜炎等疾病。女性患者的尿液标本中,尿气球菌和其他气球菌可引起侵袭性感染,应进行药物敏感试验。
(2) 气球菌属通常对β-内酰胺类、利奈唑胺和万古霉素敏感,血气球菌和绿色气球菌对左氧氟沙星耐药,尿气球菌对复方磺胺甲噁唑体外敏感,但体内敏感度取决于尿液中叶酸的浓度(与患者饮食有关),因此报告复方磺胺甲噁唑耐药。
(3) 在临床标本分离培养后在血琼脂平板上若见到草绿色溶血的小菌落,镜下形态以四联状或簇状排列为主,触酶阴性或弱阳性,在6.5%NaCl中生长,应首先考虑气球菌。
溶血孪生球菌 G.haemolysans
(一) 溶血孪生球菌形态与染色
革兰阳性球菌,但易染成革兰阴性,呈肾形,成单或成对排列,多成对排列,也可四联状或短链状排列(图 3)。

图 3溶血孪生球菌纯培养镜下形态(革兰染色)
(二) 溶血孪生球菌培养特性
在血琼脂平板上35℃培养18~24 h,形成细小、凸起、光滑、有β溶血的菌落(图 4),与溶血性链球菌很相似,某些菌株可产生α溶血或不溶血。
图 4 溶血李生球菌在血琼脂平板上的菌落特征(18~24h)
(三) 溶血孪生球菌生化反应
触酶试验为阴性。主要生化反应见表 5。
| 试验 | 结果 | 试验 | 结果 |
|---|---|---|---|
| 麦芽糖 | + | 山梨醇 | — |
| 蔗糖 | V | 碱性磷酸酶 | + |
| 乳糖 | — | 酸性磷酸酶 | + |
| 覃糖 | — | APPA | — |
| 甘露醇 | — | VP | — |
| 七叶苷 | — | 精氨酸双水解酶 | — |
| 吲哚 | — | 脲酶 | — |
注: +,90%以上菌株阳性; —,90%以上菌株阴性; V,反应不定;APPA,丙氨酸-苯丙氨酸-脯氨酸芳氨酶(alanine-phenylalanine-prolinearylamidase)
(四) 溶血孪生球菌鉴别要点
1. 本菌特征 革兰阳性球菌(容易染成阴性),菌落细小,有β溶血环,触酶试验阴性,分解葡萄糖等糖类。
2. 与无乳链球菌的鉴别 两者菌落特征、革兰染色均相似。但溶血孪生球菌CAMP试验阴性,而无乳链球菌则为阳性。
3. 与相似菌属的鉴别 见表 6。
| 特性 | 孪生球菌属 | 肠球菌属 | 链球菌属 | 无色藻菌属 | 乳球菌属 | 乏养菌属 | 片球菌属 | 格鲁比卡菌属 | 差异球菌属 | 创伤球菌 |
|---|---|---|---|---|---|---|---|---|---|---|
| 6.5% NaCl肉汤生长 | — | + | Vb | V | V | — | V | + | + | V |
| PYR | + | + | Va | — | V | + | — | + | + | + |
| LAP | V | + | + | — | + | + | + | — | + | — |
| 葡萄糖产气 | — | — | — | + | — | — | — | — | — | — |
| 七叶苷 | — | + | V | V | V | V | V | + | + | + |
| 万古霉素 | S | Vc | S | R | S | S | S | R | S | S |
注: +,90%以上菌株阳性; —,90%以上菌株阴性; S,敏感; R,耐药; V,反应不定。a. 化脓链球菌和某些肺炎链球菌PYR阳性; b. D群链球菌和草绿色链球菌群阴性,B群链球菌阳性; c. 大部分菌株敏感(除外耐万古霉素肠球菌)
4. 与属内其他菌种的鉴别 见表 7。
| 菌名 | 乳糖 | 覃糖 | 蔗糖 | 麦芽糖 | 山梨醇 | 甘露醇 | 碱性磷酸酶 | 酸性磷酸酶 |
|---|---|---|---|---|---|---|---|---|
| 麻疹孪生球菌 | — | — | + | + | V | V | — | — |
| 溶血孪生球菌 | — | — | V | + | — | — | + | + |
| 伯氏孪生球菌 | — | — | — | — | — | V | — | — |
| 大腭孪生球菌 | + | + | + | + | — | — | — | ND |
| 兔孪生球菌 | — | — | — | — | + | + | + | — |
| 血孪生球菌 | — | — | + | + | + | + | + | + |
注: +,90%以上菌株阳性; —,90%以上菌株阴性; V,反应不定; ND,无资料
(五) 溶血孪生球菌药敏试验的药物种类选择
溶血孪生球菌药敏试验的药物种类选择,见表 8。
| 抗菌药物名称 | |
|---|---|
| 必选 | 青霉素、头孢噻肟或头孢曲松、万古霉素 |
| 可选 | 左氧氟沙星、克林霉素、美罗培南、红霉素 |
注: 上述药敏试验所选药物仅有MIC判读折点,具体参照CLSI M45 - A3最新版本文件
(六) 溶血孪生球菌结果解释与要点提示
孪生球菌已经从心内膜炎病例分离到,可引起肺脓肿、菌血症、骨髓炎、心内膜炎、脑膜炎、脑脓肿、感染性休克、化脓性关节炎、腹膜炎、脓胸等疾病。麻疹孪生球菌、伯氏孪生球菌和血孪生球菌已从血培养中分离,已被证实是感染性心内膜炎的病原体。不解糖孪生球菌可从外伤伤口分泌物中分离。
本菌对青霉素、链霉素、四环素、氯霉素、万古霉素和大环内酯类等药物敏感。来自无菌部位的分离株应进行药敏试验。
麻疹孪生球菌 G.morbillorum
(一) 麻疹孪生球菌形态与染色
革兰阳性球菌,呈肾形或卵圆形,成对、短链,不形成芽胞,无荚膜,无鞭毛(图 5),菌血症或脓毒血症患者血培养标本涂片查见革兰阳性球菌(图 6)。
图 5麻疹孪生球菌纯培养镜下形态(革兰染色)

图 6 麻疹李生球菌血培养标本涂片(革兰染色)
(二) 麻疹孪生球菌培养特性
在血琼脂平板上35℃培养18~24 h,形成圆形、边缘整齐、光滑、透明的菌落,不产生色素(图 7)。
(三) 麻疹孪生球菌生化反应
触酶试验为阴性。主要生化反应见表12-9-5。

图 7 麻疹孪生球菌在血琼脂平板上的菌落特征(18~24h)
(四) 麻疹孪生球菌鉴别要点
1. 本菌特征 革兰阳性球菌(容易染成阴性),菌落细小,触酶试验阴性,分解葡萄糖等糖类。
2. 与溶血孪生球菌的鉴别 见表 9。
| 试验 | 结果 | 试验 | 结果 |
|---|---|---|---|
| 麦芽糖 | + | 山梨醇 | —(+) |
| 蔗糖 | + | 碱性磷酸酶 | — |
| 乳糖 | — | 酸性磷酸酶 | — |
| 覃糖 | — | APPA | V |
| 甘露醇 | V | VP | — |
注: +,90%以上菌株阳性; —,90%以上菌株阴性; —(+),少数菌株阳性; V,反应不定; APPA,丙氨酸-苯丙氨酸-脯氨酸芳氨酶(alanine-phenylalanine-proline arylamidase)
| 菌名 | 蔗糖 | 甘露醇 | 碱性磷酸酶 | 镜下形态 |
|---|---|---|---|---|
| 麻疹孪生球菌 | + | V | — | 成对、短链 |
| 溶血孪生球菌 | V | — | + | 成对、四联状 |
注: +,90%以上菌株阳性; —,90%以上菌株阴性; V,反应不定
3. 与其他菌属的鉴别 见表12-9-7。
| 特性 | 孪生球菌属 | 无色藻菌属 | 乳球菌属 | 片球菌属 | 创伤球菌 |
|---|---|---|---|---|---|
| PYR | + | — | V | — | + |
| LAP | V | — | + | + | — |
| 葡萄糖产气 | — | + | — | — | — |
| 七叶苷 | — | V | V | V | + |
| 万古霉素 | S | R | S | R | S |
注: +,90%以上菌株阳性; —,90%以上菌株阴性; S,敏感; R,耐药; V,反应不定。PYR,吡咯烷酮芳基酰胺酶; LAP,亮氨酸氨基肽酶
4. 与颗粒链球菌属和乏养菌属的鉴别 麻疹孪生球菌的菌落形态与颗粒链球菌属和乏养菌属相似,但可以用卫星生长现象来鉴别。
(五) 麻疹孪生球菌药敏试验的药物种类选择
参见溶血孪生球菌章节。
(六) 麻疹孪生球菌结果解释与要点提示
麻疹孪生球菌是人体口咽及肠道内共生菌丛中的条件致病菌,已有引起心内膜炎、左心房黏液瘤、脓胸、肺脓肿、脓毒性休克、脑脓肿、骨髓炎、腹膜炎等报道。
乳酸乳球菌 L. lactis
(一)乳酸乳球菌菌形态与染色
革兰阳性球菌,大小(0.5~1.2)μm×(0.5~1.5)μm,菌体呈圆形或卵圆形,成双或短链排列,无芽胞,无荚膜,无鞭毛(图 8)。

图 8乳酸乳球菌纯培养的镜下形态(革兰染色)
(二)乳酸乳球菌培养特征
在血琼脂平板上35℃培养18~24h,出现圆形、凸起、光滑、灰白色、α溶血的小菌落(图12-10-2),菌落与链球菌相似。在麦康凯琼脂平板上不生长。
(三)乳酸乳球菌生化反应
氧化酶试验和触酶试验均阴性,主要生化反应见表 11。
| 试验 | 结果 | 试验 | 结果 |
|---|---|---|---|
| 麦芽糖 | + | 木糖 | - |
| 蔗糖 | V | 乳糖 | V |
| 半乳糖 | + | PYR | + |
| 甘露醇 | (+) | 精氨酸双水解酶 | + |
| 山梨醇 | - | 马尿酸钠 | - |
| 海藻糖 | + | β半乳糖苷酶 | + |
注:+,90%以上菌株阳性;-,90%以上菌株阴性;V,11%~89%菌株阳性;(),延迟反应;PYR,吡咯烷酮芳基酰胺酶
(四)乳酸乳球菌鉴别要点
1. 本菌特征 革兰阳性球菌,触酶试验阴性,分解糖类产酸不产气,PYR试验阳性;在胆汁七叶苷和6.5%NaCl肉汤中生长,在麦康凯琼脂平板上不生长。乳球菌生物学性状与肠球菌很相似。
2. 与肠球菌鉴别 乳酸乳球菌45℃不生长,pH9.6肉汤中不生长,在麦康凯琼脂平板上不生长。肠球菌则相反,45℃环境中、pH9.6肉汤中、麦康凯琼脂平板上均可生长。屎肠球菌分解阿拉伯糖产酸,乳酸乳球菌为阴性。
3. 乳球菌属内种之间鉴别 见表 12。

图 9 乳酸乳球菌在血琼脂平板上的菌落特征(18~24h)
| 菌名 | 麦芽糖 | 蔗糖 | 半乳糖 | 甘露醇 | 山梨醇 | 蜜二糖 | 松三糖 | 海藻糖 | 木糖 | 乳糖 | PYR | VP | 精氨酸双水解酶 | 马尿酸钠 | β半乳糖苷酶 | |
|---|---|---|---|---|---|---|---|---|---|---|---|---|---|---|---|---|
| 格氏乳球菌 | + | V | + | (+) | - | - | - | + | - | V | + | + | + | - | + | |
| 棉子糖乳球菌 | + | - | + | (+) | ND | - | + | + | - | + | + | - | + | (-) | - | - |
| 鱼乳球菌 | + | + | + | - | - | + | + | + | + | + | - | ND | - | - | + | |
| 植物乳球菌 | + | + | - | + | + | - | + | + | - | - | - | + | - | - | - | |
| 乳酸乳球菌 乳脂亚种 | - | - | + | - | - | - | - | - | - | + | - | + | - | + | + | |
| 乳酸亚种 | + | +/- | + | (-) | - | - | - | + | + | + | (-) | +/- | - | + | + | |
| 霍氏亚种 | - | - | + | - | - | - | - | + | - | + | - | + | - | + | - |
注:+,90%以上菌株阳性;-,90%以上菌株阴性;V,11%~89%菌株阳性;ND,无资料(),延迟反应;+/-,多数阳性,少数阴性。PYR,吡咯烷酮芳基酰胺酶
(五)乳酸乳球菌药敏试验的药物种类选择
乳酸乳球菌药敏试验的药物种类选择见表 13。
| 抗菌药物名称 | |
|---|---|
| 必选 | 青霉素或氨苄西林、头孢曲松、万古霉素、红霉素、克林霉素 |
| 可选 | 美罗培南、四环素、左氧氟沙星、复方磺胺甲噁唑 |
| 天然耐药 | 克林霉素 |
注:上述药敏试验所选药物仅有MIC判读折点,具体参照CLSI M45-A3文件
(六)乳酸乳球菌结果解释与要点提示
乳球菌主要从乳制品和植物产品中分离出,可通过接触水产养殖的鱼类感染,是一种条件致病菌,可引起心内膜炎、关节炎、肝脓肿、菌血症、尿路感染、眼外伤、骨髓炎、脊柱关节炎、腹膜炎、非结石性胆囊炎等疾病。从无菌体液(血液、胸腔积液、腹水、穿刺液等)中分离出乳球菌可认为是感染菌,应进行药敏试验。乳球菌引起的严重感染应联合青霉素和庆大霉素治疗。
参考文献
周庭银, 章强强 主编. 临床微生物学诊断与图解(第4版)[M]. 上海: 上海科学技术出版社, 2019.
相关产品
HZB114269:草绿色气球菌 | Aerococcus viridans
HZB910978:溶血孪生球菌 | Gemella haemolysans
HZB224067:乳酸乳球菌 | Lactococcus lactis
敬请关注灰藻生物,共筑健康未来!
— 武汉市灰藻生物科技有限公司团队敬上
灰藻生物:我们期待着与客户共同成长,共创生命科学的美好未来!
更新日期:2026-1-23
编制人:木木
审稿人:小藻